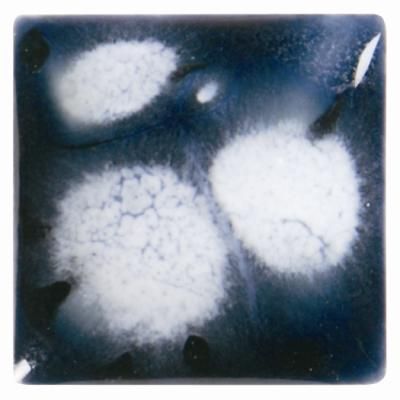

CR20088-4 BLUEBERRY ICE
9,90 €*
Nur noch 6 lieferbar.
Sofort verfügbar, Lieferzeit: 3-4 Werktage
Produktinformationen "CR20088-4 BLUEBERRY ICE"
CR20088 Blueberry Ice, halbdeckend
118 ml
Brennbereich : 1000 - 1060°C
ungiftig, kennzeichnungsfrei aber wegen crackelierter oder texturierter Oberfläche nicht für Essgeschirr empfohlen
3 Schichten mit einem weichen Pinsel auftragen (jede Schicht trocknen lassen), auf Spitzen setzen und auf 1030°C brennen
Anmelden